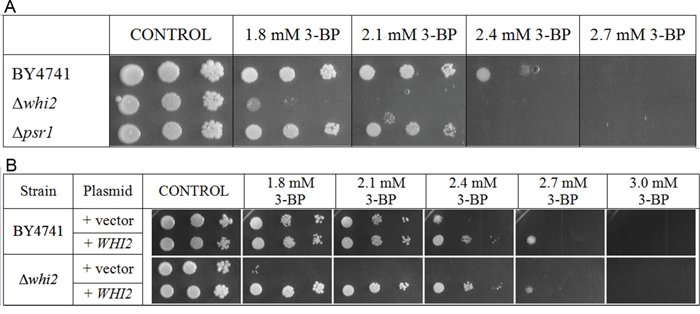

INTRODUCTION
Research using yeast Saccharomyces cerevisiae has provided much information concerning the mechanisms of cellular metabolic processes, cell cycle regulation, recombination, replication and repair of DNA as well as the cell death mechanisms, protein folding and biogenesis of organelles [1]. It is predicted that almost half of all yeast genes (about 3000) have structural or functional homologues in the human genome [2]. Further, yeast genome was the first eukaryotic genome to be fully sequenced [3], which accelerated the development of new holistic research methods, such as usage of deletion and overexpression libraries, two-hybrid analysis and microarrays [4]. Yeast model has proven its usefulness as a first-line tool in discovery of mechanisms of basic processes engaged in pathogenesis thanks to the conserved protein interaction networks. The direct contribution is the basic knowledge on the cell cycle regulation [5]. The discovery and analysis of apoptotic processes in yeast allowed better understanding of the molecular mechanisms underlying apoptosis-related diseases [6]. Heterologous expression of human proteins in yeast cells allowed understanding of the functions of many disease-related proteins leading to the identification of the disease progression mechanisms. Research using yeast has also provided relevant information regarding molecular basis of cancer, resulting in the identification of new therapeutic targets. There are certain phenotypic characteristics of yeast rendering them a perfect model system to investigate human diseases, as many of the basic cellular processes are well conserved [7]. New anticancer drugs can be tested on yeast model using specific mutant strains having some phenotype characteristics similar to cancer cells (such as faulty cell cycle control). For example, the molecular mechanisms of topoisomerase II inhibitors, used as anticancer drugs, were identified using 70 yeast strains with defective checkpoint control and faulty DNA repair [8]. Usage of proper mutants also allows testing for sensitivity, resistance mechanisms to new drugs as well as synergistic interactions with other drugs [9].
Like cancer cells, fermenting yeast exhibit overexpression of glycolytic enzymes in response to high glucose availability. Activity of the key enzymes (i.e., hexokinase, phosphofructokinase and pyruvate kinase) is highly increased. When growing on glucose, predominantly expressed isoform of hexokinase is HK II which is insensitive to inhibition by its product [10]. Furthermore, the first isoform of pyruvate kinase (Pyk1p), which is more susceptible to allosteric activation by fructose 1,6-bisohosphate, is strongly expressed. Because of high cytoplasmic metabolism of pyruvate only a small amount is oxidized and utilized in the Krebs cycle [11]. Together with decreased rate of TCA, the enzymatic activities of aconitase, isocitrate dehydrogenase and malate dehydrogenase are diminished [12]. Homologues of mammalian PDK (pyruvate dehydrogenase kinase) enzymes (Pdhk) and corresponding phosphatases (Pdp) are present in yeast [13]. The activity of yeast pyruvate dehydrogenase is regulated by its phosphorylation. The inactive dephosphorylated form is present mainly in cells growing on nonfermentable carbon sources, thus generating ATP through oxidative phosphorylation [14]. The pyruvate dehydrogenase complex is also regulated through its E3 subunit (lipoamide dehydrogenase), which expression is decreased during fermentative metabolism [15]. Lactate dehydrogenase occurs in yeast as two isoforms localized in the inner mitochondrial membrane. These enzymes irreversibly convert lactate into pyruvate and take part in the respiratory chain. The cytosolic form of lactate dehydrogenase is still unknown in yeast [16]. In yeast the direction of pyruvate metabolism in cytosol is mainly dependent on pyruvate decarboxylase (Pdc) activity [17]. Pdc converts pyruvate into acetaldehyde which is then oxidized in mitochondria [18] or reduced to ethanol by alcohol dehydrogenase (Adh). Although the metabolism of pyruvate in yeast and mammalian cells is not identical, still the general mechanism is the same – increased flux of this pathway diminishes the availability of substrates for aerobic metabolism, as it is in the case of hyperactive LDH in cancer cells. All these suggest that during intense fermentation, Pdc activation is strictly connected to the repression of mitochondrial respiration [19].
Metabolic similarities between fermenting yeast cells and tumor cells allow the research concerning metabolism-targeting anti-cancer drugs, e.g., 3-bromopyruvate. 3-BP is a structural analog of pyruvic acid and is highly reactive - it shows strong alkylating properties toward proteins. The pyruvic chain covalently binds to the cysteine and histidine residues changing the protein conformation and activity. 3-BP is also a putative inhibitor of all reactions involving pyruvate. Additionally, it was shown to inhibit hexokinase II [20]. During the tests on rats, mice and rabbits 3-BP exhibited high anticancer activity [21, 22]. All of the rats carrying a hepatoma which were treated with 3-BP, were fully cured with no recurrence. About 70% of cancer cells were killed after one administration and after 4 weeks of treatment the rats fully recovered [22].
The mechanism of selective anticancer effect of 3-BP is still not fully clarified. 3-BP probably inhibits glycolysis by acting on enzymes catalyzing reactions involving pyruvate (i.e., LDH, PC and PDH) leading to ATP depletion. 3-BP is also thought to cause inhibition of hexokinase II, which may lead to apoptosis of the cell [20, 22, 23]. Moreover, it was shown in vitro that 3-BP is able to alkylate glyceraldehyde 3-phosphate dehydrogenase (GAPDH) leading to its inhibition [24]. It is also assumed that 3-BP causes generation of reactive oxygen species (ROS) which are highly toxic for the cell [25]. It was shown that depletion of the intracellular glutathione strongly increased sensitivity of yeast cells to 3-BP, which suggests that 3-BP causes oxidative stress and may deplete the pool of reduced glutathione itself [26], which has also been shown in human erythrocytes [27]. The specific activity of 3-BP toward cancer cells may be also due to the selective uptake into the cells. 3-BP was shown to enter the cells through the Monocarboxylate Transporters (MCT), transporters of lactate and pyruvate. Research in breast cancer cells shown that butyrate, which induces the expression of monocarboxylate transporter MCT4, causes increased sensitivity to 3-BP [28]. It was also shown using the KBM7 human myeloid leukemia cell line, that MCT1 mediates the uptake of 3-BP and that deletion of the MCT1 results in resistance to 3-BP [29]. Moreover, it was recently presented that higher expression of MCT1 in multiple myeloma cells correlated with increased uptake of 3-BP, when compared to the control cells [30]. The characteristics of transport of 3-BP into human erythrocytes was described very recently [31]. Our recent research on 3-BP using the yeast model showed that it enters the yeast cell mainly through the lactate/pyruvate-H+ permease Jen1p and that it is not a substrate for the multidrug resistance PDR efflux pumps [26]. We also showed that 3-BP is a potent antifungal agent with very selective toxicity toward the human pathogen Cryptococcus neoformans [32].
This is the first report showing multidirectional influence of 3-BP on the yeast Saccharomyces cerevisiae, a very useful model system for genomic screen of deletion mutants defective in the energetic metabolism.
RESULTS
General toxicity of 3-BP in the yeast Saccharomyces cerevisiae and its influence on the intracellular ATP levels
It was crucial to determine general toxicity of 3-BP in Saccharomyces cerevisiae strains and its influence on the intracellular ATP levels. The minimal synthetic medium (SD) was chosen for all of the experiments and different carbon sources were tested using the spot-test method in the wild-type W303-1A strain. These preliminary tests showed that glucose and other repressing sugars cause relative insensitivity to 3-BP (no visible effect at concentrations up to 3 mM in the wild-type), whereas nonfermentable and non-repressing carbon sources render wild-type yeast sensitive to 3-BP in the range of 1.5-2.5 mM, depending on a strain. These results suggested that the uptake mechanism of 3-BP could be glucose-repressible. Henceforth, most of the experiments were performed using sucrose as a sole carbon source in culture media, unless it is stated differently.
Direct impact on cellular ATP levels and cell viability in liquid culture of yeast during the first 5 hours of exposition was determined. 3-BP concentrations of 1.8 mM (a sub-MIC value) and 3 mM (1.5-fold MIC) were chosen for the experiment. ATP level values shown are recalculated per living cell, to show the change in ATP level in living cells, neglecting the ATP fall caused by decreasing amount of cells being alive. The wild-type W303-1A (Figure 1A) and a respiratory deficient mutant (containing no mitochondrial DNA) W303-1A rho0 (Figure 1B) were chosen for the test.

Figure 1: Intracellular ATP levels and viability in the parental wild type W303-1A A. and W303-1A rho0 mutant B. strains are decreased under 3-BP treatment. The cells were incubated for 5 hours in minimal medium with sucrose with 1.8 mM 3-BP and 3 mM 3-BP. Bars represent viability of the cells at each time-point. The ATP levels are recalculated per living cells, taking the positive control (medium without 3-BP) as 100%. C. A spot-test showing 3-BP sensitivity in the wild-type W303-1A strain and the W303-1A rho0 respiratory mutant. Incubation time: 72 h.
In the wild-type W303-1A in the first hour of the experiment, concentration of 1.8 mM of 3-BP did not cause any effect on the intracellular ATP levels, however it decreased the strain viability to about 70%. 3 mM caused similar viability decrease, however simultaneous fall to under 60% in the level of ATP occurred. In the W303-1A rho0 respiratory mutant the effect on the ATP levels was significantly stronger (about 60% and 35% of the control, for 1.8 mM and 3 mM 3-BP, respectively), however showing weaker influence on viability. In the second and third hour of incubation further decrease in ATP levels was shown for both strains, however viability was more affected in the wild-type W303-1A. In the fifth hour of the experiment both concentrations of 3-BP dropped the ATP levels to about 20% of control in the wild-type strain. Also in the respiratory deficient mutant 3 mM of 3-BP caused decrease of ATP to about 20%, however 1.8 mM 3-BP only to about 35%. The viability of both strains when treated with 1.8 mM was about 80%. When 3 mM 3-BP was used the wild-type viability decreased to under 40%, whereas the rho0 maintained viability of 60%.
It can be concluded that the decrease of ATP levels is more rapid in the rho0 respiratory-deficient mutant, however, it is not as strong as in the wild-type in the long-term perspective. Generally, the rho0 remained more viable during the experiment, regardless of the 3-BP concentration used, showing that the presence of functional mitochondria causes increased overall sensitivity to 3-BP.
The differences in susceptibility of the wild-type W303-1A and the mitochondrial respiratory mutant W303-1A rho0 to 3-BP were also tested using the spot-test method (Figure 1C). The respiratory mutant exhibited increased resistance to 3-BP comparing to wild-type W303-1A, confirming the results of experiment determining the ATP levels and viability after 3-BP treatment.
Toxicity of 3-BP in yeast mutants with disrupted glycolytic and TCA enzymes
Taking into account that 3-BP acts on the energetic metabolism of the cell, an experiment was carried out in order to check whether absence of specific glycolytic and respiratory enzymes may have influence on susceptibility to 3-BP. A set of 40 yeast strains from the EUROSCARF collection having deleted single genes encoding proteins engaged in glycolysis and TCA cycle were tested.
The summary of spot-tests showing the effect of a specific mutation on 3-BP susceptibility is shown in Table 1.
Table 1: The summary of spot-tests showing the influence of 3-BP on yeast mutants with disrupted glycolytic and respiratory enzymes
STRAIN |
DISRUPTED ENZYME |
PHENOTYPE |
C+ |
1.2 mM 3-BP |
1.5 mM 3-BP |
1.8 mM 3-BP |
2.1 mM 3-BP |
2.4 mM 3-BP |
2.7 mM 3-BP |
|---|---|---|---|---|---|---|---|---|---|
BY4741 |
Wild-type |
|
+++ |
+++ |
+++ |
+++ |
+++ |
+ |
– |
Δhxk1 |
hexokinase-1 |
– |
+++ |
+++ |
+++ |
+++ |
+++ |
+ |
– |
Δhxk2 |
hexokinase-2 |
– |
+++ |
+++ |
+++ |
+++ |
+++ |
+ |
– |
Δglk1 |
glucokinase |
R |
+++ |
+++ |
+++ |
+++ |
+++ |
++ |
– |
Δpfk1 |
phosphofructokinase alpha |
HR |
+++ |
+++ |
+++ |
+++ |
+++ |
+++ |
+ |
Δpfk2 |
phosphofructokinase beta |
R |
+++ |
+++ |
+++ |
+++ |
+++ |
++ |
0 |
Δfbp1 |
fructose-1,6-bisphosphatase |
R |
+++ |
+++ |
+++ |
+++ |
+++ |
+++ |
0 |
Δtdh1 |
3-P-glyceraldehyde dehydrogenase |
– |
+++ |
+++ |
+++ |
+++ |
+++ |
+ |
0 |
Δtdh2 |
3-P-glyceraldehyde dehydrogenase |
– |
+++ |
+++ |
+++ |
+++ |
+++ |
+ |
0 |
Δtdh3 |
3-P-glyceraldehyde dehydrogenase |
– |
+++ |
+++ |
+++ |
+++ |
+++ |
+ |
0 |
Δeno1 |
enolase-1 |
R |
+++ |
+++ |
+++ |
+++ |
+++ |
+++ |
0 |
Δeno2 |
enolase-2 |
– |
+++ |
+++ |
+++ |
+++ |
+++ |
+ |
0 |
Δpyk2 |
pyruvate kinase |
R |
+++ |
+++ |
+++ |
+++ |
+++ |
++ |
0 |
Δcit1 |
citrate synthase |
– |
+++ |
+++ |
+++ |
+++ |
+++ |
+ |
0 |
Δcit3 |
citrate synthase |
R |
+++ |
+++ |
+++ |
+++ |
+++ |
++ |
0 |
Δaco1 |
aconitase |
– |
+++ |
+++ |
+++ |
+++ |
+++ |
+ |
|
Δaco2 |
aconitate hydratase |
S |
+++ |
+++ |
+++ |
+++ |
+++ |
0 |
0 |
Δidh1 |
NAD-dependent isocitrate dehydrogenase |
S |
+++ |
+++ |
+++ |
+++ |
0 |
0 |
0 |
Δidh2 |
NAD-dependent isocitrate dehydrogenase |
S |
+++ |
+++ |
+++ |
+++ |
+ |
0 |
0 |
Δkgd1 |
alpha-ketoglutarate dehydrogenase |
HS |
+++ |
+++ |
+++ |
0 |
0 |
0 |
0 |
Δkgd2 |
alpha-ketoglutarate dehydrogenase |
– |
+++ |
+++ |
+++ |
+++ |
+++ |
+ |
0 |
Δlpd1 |
lipoamide dehydrogenase (subunit of mitochondrial PDH complex) |
S |
+++ |
+++ |
+++ |
+++ |
+ |
0 |
0 |
Δsdh1 |
succinate dehydrogenase flavoprotein subunit |
S |
+++ |
+++ |
+++ |
+++ |
++ |
0 |
0 |
Δmdh1 |
mitochondrial malate dehydrogenase |
S |
+++ |
+++ |
+++ |
+++ |
++ |
0 |
0 |
Δpdx1 |
pyruvate dehydrogenase complex protein X |
– |
+++ |
+++ |
+++ |
+++ |
+++ |
+ |
0 |
Δpyc1 |
pyruvate carboxylase |
HS |
+++ |
++ |
0 |
0 |
0 |
0 |
0 |
Δpyc2 |
pyruvate carboxylase |
– |
+++ |
+++ |
+++ |
+++ |
+++ |
+ |
0 |
Δdld1 |
D-lactate dehydrogenase |
– |
+++ |
+++ |
+++ |
+++ |
+++ |
+ |
0 |
Δcyb2 |
L-lactate cytochrome-c oxidoreductase |
– |
+++ |
+++ |
+++ |
+++ |
+++ |
+ |
0 |
Δpdc1 |
pyruvate decarboxylase |
R |
+++ |
+++ |
+++ |
+++ |
+++ |
+++ |
0 |
Δadh1 |
alcohol dehydrogenase |
R |
+++ |
+++ |
+++ |
+++ |
+++ |
++ |
0 |
Δacs1 |
acetyl-coA synthetase |
– |
+++ |
+++ |
+++ |
+++ |
+++ |
+ |
0 |
Δald4 |
mitochondrial aldehyde dehydrogenase |
– |
+++ |
+++ |
+++ |
+++ |
+++ |
+ |
0 |
Δald6 |
cytosolic aldehyde dehydrogenase |
– |
+++ |
+++ |
+++ |
+++ |
+++ |
+ |
0 |
Δicl1 |
isocitrate lyase |
R |
+++ |
+++ |
+++ |
+++ |
+++ |
++ |
0 |
Δmls1 |
malate synthase-1 |
– |
+++ |
+++ |
+++ |
+++ |
+++ |
+ |
0 |
Δmdh2 |
cytoplasmic malate dehydrogenase |
– |
+++ |
+++ |
+++ |
+++ |
+++ |
+ |
0 |
Δpck1 |
phosphoenolpyruvate carboxykinase |
– |
+++ |
+++ |
+++ |
+++ |
+++ |
+ |
0 |
Δzwf1 |
glucose-6-phosphate dehydrogenase |
HS |
+++ |
++ |
+ |
0 |
0 |
0 |
0 |
Δtkl1 |
transketolase |
S |
+++ |
+++ |
+++ |
+++ |
++ |
0 |
0 |
Δtal1 |
transaldolase |
S |
+++ |
+++ |
+++ |
+++ |
+++ |
0 |
0 |
The 3-BP sensitive/resistant phenotype of each strain is specified, comparing to the wild-type BY4741. Comparison of 3-BP sensitivity in the wild-type BY4741 strain and isogenic mutants with deleted HXK1, HXK2, GLK1, PFK1, PFK2, FBP1, TDH1, TDH2, TDH3, ENO1, ENO2, PYK2, CIT1, CIT3, ACO1, ACO2, IDH1, IDH2, KG1, KGD2, LPD1, SDH1, MDH1, PDX1, PYC1, PYC2, DLD1, CYB2, PDC1, ADH1, ACS1, ALD4, ALD6, ICL1, MLS1, MDH2, PCK1, ZWF1, TKL1 and TAL1 genes.
S – sensitive; HS – highly sensitive; R – resistant; HR – highly resistant; - – no change comparing to wild type; +++ – growth from dilutions 100, 10-1, 10-2; ++ – growth from dilutions 100, 10-1; + – growth from dilution 100; 0 – no growth.
Deletion of genes encoding cytosolic enzymes caused highly resistant phenotype in the case of phosphofructokinase alpha (PFK1) and moderate resistance in the case of glucokinase (GLK1), phosphofructokinase beta (PFK2), pyruvate kinase (PYK2), pyruvate decarboxylase (PDC1), alcohol dehydrogenase (ADH1), fructose-1,6-bisphosphatase (FBP1), enolase-1 (ENO1) and isocitrate lyase (ICL1). Hypersensitivity to 3-BP was observed in glucose-6-phosphate dehydrogenase (ZWF1) and pyruvate carboxylase (PYC1) mutants and moderate sensitivity in transketolase (TKL1) and transaldolase (TAL1).
Deletion of genes encoding mitochondrial enzymes and subunits caused high sensitivity in the case of alpha-ketoglutarate dehydrogenase (KGD1) and sensitive phenotype in the case of isocitrate dehydrogenases (IDH1) and (IDH2), lipoamide dehydrogenase (LPD1), aconitate hydratase (ACO2), mitochondrial malate dehydrogenase (MDH1) and succinate dehydrogenase flavoprotein subunit (SDH1) mutants. Resistant phenotype was observed in the case of citrate synthase (CIT3).
As the metabolism and flux of pyruvate may be crucial to identify the mechanism of action of 3-BP, the influence of functionality of the Mitochondrial Pyruvate Carrier (Mpc) on susceptibility to 3-BP was checked. There are three genes in yeast taking part in encoding the mitochondrial pyruvate carrier, i.e., MPC1, MPC2 and MPC3, with the first one being crucial for its function. The results of the performed spot-test are presented in Figure 2A. Comparing to the wild-type, the Δmpc1 mutant clearly showed increased sensitivity to 3-BP with just a minimal effect in the Δmpc2 strain and no visible effect in the Δmpc3 strain.

Figure 2: Influence of mutations in selected genes encoding factors involved in the regulation of the glucose-repression and mitochondrial pyruvate carrier as well as the mitochondrial porin, mitochondrial phosphate carrier and mitochondrial oxaloacetate carrier on sensitivity to 3-BP. A. Deletion of each of the POR1, MIR1 and OAC1 genes resulted in increased sensitivity to 3-BP. The Δmpc1 mutant showed the strongest effect in increased of sensitivity to 3-BP, weaker effect was noted for Δmpc2. Incubation time: 72 h. B. Among mutants which were deleted in genes encoding proteins involved in the glucose-repression/derepression system: TPK1, MIG1, CAT8 and YCK1 all tested strains showed sensitivity to 3-BP except Δcat8 which was resistance to 3-BP. Incubation time: 72 h.
Three other mitochondrial membrane proteins, i.e., the mitochondrial porin Por1p (VDAC), mitochondrial phosphate carrier (Mir1p) and mitochondrial oxaloacetate carrier (Oac1p) were also tested (Figure 2A). Deletion of each of the POR1, MIR1 and OAC1 genes resulted in increased sensitivity to 3-BP.
The influence of deletion of genes encoding factors involved in the regulation of the glucose-repression system on 3-BP sensitivity was also tested. Δtpk1 strain, having inactive PKA (cAMP-dependent protein kinase) and both, Δmig1 and Δyck1 strain have defective glucose repression [33, 34]. Δcat8 cells cannot activate the gluconeogenic pathway and are unable to grow on unfermentable carbon sources, having faulty glucose derepression. Δtpk1, Δmig1 and Δyck1 strains exhibited sensitivity to 3-BP, whereas Δcat8 showed resistance comparing to the wild type (Figure 2B).
Overexpression of the Whi2p causes resistance to 3-BP in yeast cells
Using yeast multicopy genomic cDNA library (Lacroute) for FY1679-28C strain transformation, nine transformants hyper-resistant to 3-BP were isolated. The resistant phenotype of the selected transformants was confirmed using the spot-test method. Plasmid DNA from resistant transformants was isolated and sequenced. All of the isolated plasmids contained similar parts (lengths of 4 – 7 kb) of XV chromosome. The common part of these sequences was the WHI2 gene.
It was shown that overexpression of Whi2p renders the cells elongated and 3-fold larger than the wild-type. Moreover, the cells are unable to complete cytokinesis and the budding pattern becomes polar instead of axial, resulting in filamentous growth [35]. It has been suggested that Whi2p connects Ras2p to the Ras-protein kinase A (PKA) signaling pathway, by influencing Ras2p localization. It was reported that lack of functional Whi2p results in actin aggregation, which may trigger apoptosis on the Ras-PKA pathway. It may also result in mitochondrial damage during the diauxic shift [36].
One of the pathways of the general stress response in yeast is through Msn2p and Msn4p transcription factors. They lead to the expression of many stress responsive genes through binding to the STRE (stress response elements). It was shown that STRE-mediated gene expression under stress conditions is strongly reduced in cells with deletion of the WHI2 gene, comparing to the wild-type. Moreover Δwhi2 cells reach the stationary phase several hours later than the wild-type. Furthermore, Δwhi2 mutant is unable to accumulate storage glycogen [37]. Normally, when yeast cells are starved, they arrest in G1 phase of the cell cycle and change their metabolism to be able to survive the unfavorable conditions. Δwhi2 mutant cells do not exhibit this response to starvation, they carry on dividing and the mutant cells in stationary phase become much smaller than in WT. They also often arrest randomly in the cell cycle [38].
It was also shown that Whi2p is required for the TOR-controlled induction of mitophagy of the dysfunctional mitochondria [39]. However, solely fragmentation of mitochondria is not enough to trigger its degradation. The pathway of mitophagy is independent of the mechanism of mitochondrial fission and it is suggested that Whi2p links the mitophagy machinery to the Ras-PKA signaling pathway [45].
To confirm that Whi2p is engaged in resistance to 3-BP, a mutant strain with WHI2 gene deleted was tested.
The Δwhi2 strain in comparison to the wild-type shows strongly increased susceptibility to 3-BP (Figure 3A). However, growth of the Δpsr1 mutant (which has deletion of the PSR1 gene, encoding a binding partner of Whi2p) was only slightly weaker than of the wild-type.
Figure 3: Δwhi2 deletion mutant showed sensitivity to 3-BP in BY4741 background. A. Comparison of 3-BP sensitivity in the wild-type BY4741 strain and isogenic mutants with WHI2 and PSR1 genes deleted. Deletion of WHI2 gene strongly increased susceptibility to 3-BP, in contrast to Δpsr1 where observed sensitivity is weaker. Incubation time: 72h. B. The wild-type BY4741 strain and isogenic Δwhi2 strain were transformed with a multicopy plasmid (pFl44L) containing WHI2 gene, and as a control with an empty plasmid. Incubation time: 72h.
To check whether expression of the WHI2 gene from plasmid restores the resistance to 3-BP in the Δwhi2 mutant, a spot-test using the Δwhi2 and the wild-type strain with multicopy plasmid containing the WHI2 gene and an empty pFL44L plasmid as a control was carried out. The presence of a multicopy plasmid with the WHI2 gene increased resistance to 3-BP almost equally, both in the wild type BY4741 and the Δwhi2 strain (Figure 3B).
It can be concluded that presence of Whi2p phosphatase is essential for resistance to 3-BP in yeast, as its overexpression increases resistance to whereas its deletion results in greater susceptibility to 3-BP.
Deletion of both Whi2p binding partners, Psr1p and Psr2p, causes increased sensitivity to 3-BP
The plasma membrane phosphatases Psr1p and Psr2p were found (using the two-hybrid system) to interact directly with Whi2p [40]. The double Δpsr1Δpsr2 mutant exhibits similar phenotype properties to the Δwhi2 strain, i.e., reduced STRE-mediated gene expression, hyperphosphorylation of the Msn2p/Msn4p factors, higher sensitivity to stress (such as heat shock or sodium stress). Interaction of Psr1p, Msn2p and Whi2p was shown by immunoprecipitation experiments [43]. It is possible that Whi2p is a necessary adaptor between Msn2p and Psr1p which allows direct dephosphorylation of Msn2p by Psr1p phosphatase. These data suggest that Whi2p together with Psr1p/Psr2p are needed for activation of the general stress response by interacting with Msn2p [43]. However, Whi2p and Psr1p/Psr2p are just three of many other activators of Msn2p/Msn4p pathway (e.g., Mck1p, Snf1p, Hog1p kinases) [41].
To check whether Whi2p-mediated resistance occurs on the known pathway due to its binding with Psr1p/Psr2p phosphatases, single Δpsr1 and Δpsr2 mutants and a double mutant Δpsr1Δpsr2 in the W303-1A background were constructed and tested (Figure 4). None of the single Δpsr1 and Δpsr2 mutants showed different sensitivity to 3-BP than the wild-type. This is different than in the BY4741 background, where the single Δpsr1 showed slightly increased sensitivity. However, in the W303-1A background, double Δpsr1Δpsr2 mutant showed increased susceptibility to 3-BP comparing to wild-type and the single-mutants. It should be noticed, this effect was not as strong as in Δwhi2 mutant.

Figure 4: In W303 background Δwhi2 as well as Δpsr1Δpsr2 mutants showed sensitivity to 3-BP, whereas Δpsr1 did not. Comparison of 3-BP sensitivity between the wild-type W303-1A and isogenic Δwhi2, Δpsr1, Δpsr2 and Δpsr1Δpsr2 strains. Incubation time: 72 h.
Whi2-mediated resistance to 3-BP does not occur through interaction with the HOG stress response pathway
The following proteins: Whi2p/Psr1p, Msn2p, Msn4p and Hog1p are essential for the initiation of general stress response pathway in yeast [42]. Under stress condition Whi2p/Psr1p phosphatase complex probably activates Msn2p and Msn4p, which may activate the Hog1p kinase.
Results in Figure 5A show that Whi2p-mediated resistance phenotype in yeast is probably independent of general stress response pathway. Deletions of genes encoding Msn2p and Msn4p do not seem to have any negative effects on yeast grown on 3-BP. Transformation with multicopy plasmid containing the WHI2 gene improves resistance to similar levels in every strain tested (Δwhi2, Δmsn2, Δmsn4, WT) which also suggests that resistance to 3-BP conferred by Whi2p is not due to upregulation of the HOG pathway (Figure 6). What is more, strain with deleted HOG1 gene (in BY4741 background) shows slightly increased resistance to 3-BP. As the HOG pathway is responsible for resistance to osmotic stress, growth characteristics were compared to growth on medium with sodium chloride as a control (Figure 5B). These results show that Whi2p-mediated resistance to 3-BP probably does not occur via the HOG stress response pathway. Increased resistance may occur either because of direct Whi2p phosphatase activity or due to existence of other unidentified signaling pathway leading to other effectors than Hog1p.

Figure 5: Whi2p-mediated resistance to 3-BP probably does not occur via the HOG stress response pathway. A. Comparison of 3-BP sensitivity in the wild-type BY4741 strain and isogenic mutants with WHI2, PSR1, MSN2, MSN4 and HOG1 genes deleted. B. Strainscontrol on medium with sodium chloride. Incubation time: 72 h.

Figure 6: Transformation with multicopy plasmid containing the WHI2 gene improves resistance to similar levels of 3-BP in every strain tested (Δwhi2, Δmsn2, Δmsn4, WT). Growth of BY4741, Δwhi2, Δmsn2, Δmsn4 and Δhog1 strains carrying multicopy plasmid (pFL44L) containing WHI2 gene or an empty plasmid as a control. Incubation time: 72 h.
Whi2 and Jen1 influences on sensitivity to 3-BP seem to be independent
As the Whi2p has a pleiotropic activity, it was checked if its influence on 3-BP sensitivity is connected with its possible regulatory effect on expression and/or activity of the Jen1p permease, which was shown to transport 3-BP in yeast [26, 43]. To check whether the resistance caused by deletion of JEN1 is connected with the resistance caused by the overexpression of WHI2, a single Δwhi2 mutant and a double mutant Δjen1Δwhi2 were constructed in the W303-1A background (Figure 7).

Figure 7: Function of Whi2 and Jen1 is independent in response to 3-BP. Comparison of 3-BP sensitivity in the wild-type W303-1A and isogenic Δwhi2, Δjen1 and a double Δjen1Δwhi2 mutant. Incubation time: 96 h.
Both, Δwhi2 and double Δjen1Δwhi2 strains exhibited increased sensitivity to 3-BP comparing to the wild-type and a single Δjen1 mutant. However the Δjen1Δwhi2 strain was proportionally more resistant to 3-BP comparing to the Δwhi2 strain, thus suggesting that the effect of Whi2p is probably independent of the effect of Jen1p.
DISCUSSION
3-BP, a small-molecule alkylating agent has been shown to be a potent and specific anticancer drug. 3-BP differs in the mode of action from the currently available chemotherapeutics, as it directly targets the energy metabolism of a cancer cell. Inhibition of both glycolysis and mitochondrial oxidative phosphorylation leads to rapid ATP depletion and apoptotic or necrotic cell death. Moreover 3-BP exhibits little or no effect on normal healthy cells. In this study the characteristics of 3-BP toxicity in the yeast model are described, with the emphasis on its influence on energetic metabolism of the cell and chosen regulatory pathways.
The results of the experiment showing direct influence of 3-BP on intracellular ATP levels in yeast, suggest that the mitochondrial respiration enzymatic machinery may be more sensitive to 3-BP than glycolysis, still of course both pathways being inhibited, as it was shown to happen in human cancer cells [44, 30]. Despite the fact that in the first hour of incubation ATP decrease is stronger in rho0 respiratory deficient mutant, it retains higher ATP levels at the end of the incubation and shows higher viability than the wild-type strain. The ATP depletion in the first hour is probably stronger in rho0 cells because glycolysis is its main source of energy and in the wild-type it takes time to affect the mitochondria and deplete the respiratory substrates and the TCA intermediates. This can be also due to the fact that loss of the mitochondrial genome in rho0 mutant triggers global reprogramming of gene expression called the retrograde response, which is a set of signaling pathways leading from the mitochondria to the nucleus [45]. It triggers expression of the nuclear CIT2 gene, encoding citrate synthase-2, to ensure proper levels of α-ketoglutarate, which is a crucial precursor for the amino acids biosynthesis [46]. It was also shown that rho0 cells dramatically induce expression of ABC transporter-encoding genes like PDR5, as well as exhibit elevated transcription of loci encoding enzymes involved in sphingolipid biosynthesis [47]. This is however not in this case, as it was shown that 3-BP is not a substrate for the yeast PDR system [26]. The retrograde regulation, which has been shown to be controlled by the Rtg1p, Rtg2p and Rtg3p factors, results in increased expression of genes involved in anaplerotic pathways, transport of small molecules, as well as upregulated peroxisomal activities and stress responses. It increases over 10-fold expression of CIT2 gene (encoding a glyoxylate cycle citrate synthase), DLD3 (encoding a cytosolic D-lactate dehydrogenase) and PDH1 (encoding protein involved in propionate metabolism) [48]. In cells with dysfunctional mitochondria expression of genes encoding enzymes of the TCA cycle that lead to the production of α-ketoglutarate (i.e., CIT1, ACO1, IDH1 and IDH2) is dependent on the RTG genes, unlike cells with normal mitochondrial function, where they are regulated by HAP2,3,4,5 transcription complex [49]. Independent regulation of these genes, as well as upregulation of the anaplerotic pathways may be responsible for increased resistance to 3-BP of the rho0 cells. The 3-BP-resistant phenotype of rho0 mutants was also shown in Candida glabrata (unpublished data). The expression of pyruvate carboxylase (PYC1) and acetyl-CoA synthase (ACS1) is also upregulated in rho0 cells. Moreover, flux of metabolites from β-oxidation of fatty acids and glyoxylate cycle are upregulated [54]. Pyc1p supplies oxaloacetate for gluconeogenesis and to replenish tricarboxylic acid cycle intermediates [50]. Overexpression of PYC1 could be a probable determinant of 3-BP-resistance in the rho0 cells, as its deletion causes sensitivity to 3-BP.
Concerning the first step of glycolysis in yeast, hexokinase-2 (Hxk2p) is the predominant isoform when glucose is abundant, however upon glucose depletion its expression is repressed and hexokinase-1 (Hxk1p) and glucokinase (Glk1p) become active. Hxk1p and Glk1p function redundantly, their expression is upregulated in the absence of the other one [51]. Though not strong, resistance of Δglk1 strain to 3-BP may suggest that Glk1p could be more susceptible to inhibition by 3-BP than Hxk1p. In human cells it is proposed that hexokinase-2 is the isoform sensitive to 3-BP [20].
Glucose-6-phosphate is a substrate for further glycolytic processing, however, it may be entering the pentose phosphate pathway (PPP) instead. Deletion of the ZWF1 gene encoding 6-phosphoglucose dehydrogenase, the enzyme catalyzing the first and rate-limiting step of the pentose phosphate pathway, resulted in increased sensitivity to 3-BP. Similar effect was visible in the Δtal1 mutant, lacking the enzyme transaldolase, which creates a reversible link between two the PPP and glycolysis [52]. The 3-BP-sensitive phenotype which is observed when the pentose phosphate pathway is disrupted may be explained by the fact, that PPP is a crucial source of NADPH, which acts as a cellular reducing power. NADPH provides the reducing potential for most of the antioxidant enzymes, such as glutathione and thioredoxin systems. As pentose phosphate pathway is directly connected to the glycolytic pathway, any change in activity of glycolytic enzymes may influence the flux of PPP, resulting in change of the amounts of NADPH produced [53]. It was previously shown that disruption of the ZWF1 gene resulted in decreased resistance to oxidants, confirming the role of PPP in the oxidant tolerance mechanism [54]. Gorsich et al. showed that PPP mutants were inefficient at reducing furfural resulting in higher sensitivity to this inhibitor, as well as to 5-hydroxymethylfurfural [55]. Moreover, previous studies showed correlation between resistance to sorbic acid and activity of several PPP enzymes [56].
The lack of a phosphofructokinase (PFK) probably forces the upregulation of the PPP, resulting in higher levels of NADH, which leads to enhanced glutathione reduction and increased 3-BP resistance. It is also known that strain with deleted PFK1 gene, encoding the catalytic subunit of phosphofructokinase-1 show no Pasteur effect [57].
Moreover, induction of gluconeogenesis leads to a higher production of glucose-6-phosphate, the key substrate for the pentose phosphate pathway [58]. This would be confirmed by the 3-BP-sensitive phenotype of the Δpyc1 (pyruvate carboxylase-1), as this mutation blocks formation of oxaloacetate from pyruvate, which is a crucial step of gluconeogenesis. In the case of Δpyc1 the effect may be also due to the decreased anaplerosis of the TCA cycle, caused by low levels of oxaloactetate, which hypothesis is supported by 3-BP-sensitivity of the Δoac1 mutant lacking the mitochondrial oxaloacetate carrier [59].
On the other hand, lack of other gluconeogenic enzyme, namely fructose-1,6-bisphosphatase (Fbp1p), resulted in resistance to 3-bromopyruavte. Expression profiles showed that genes induced by the diauxic shift are induced by oxidative stress, DNA damage and other stress conditions [63]. It was shown that fructose-1,6-bisphosphatase is also involved in ROS production in chronologically aged cells and after MMS treatment. Absence of FBP1 resulted in better survival of cells treated with MMS, improved surviving of aged cells and delayed the induction of ROS production [63], which is consistent with the 3-BP-resistant phenotype.
Disruption of pyruvate decarboxylase (PDC) and aldehyde dehydrogenease (ADH) causes the pyruvate to enter the TCA cycle or gluconeogenesis rather than the pathway of ethanol production, which agrees with the fact that active glucoeneogenesis seems to diminish the toxicity of 3-BP. Deletion of gene enoding pyruvate kinase (PYK2) results in increased resistance to 3-BP, possibly also beacuse phospho-enolpyruvate is forced into the gluconeogenic pathway.
Deletion of genes encoding TCA enzymes, i.e., ACO2, IDH1, IDH2, KGD1, LPD1, SDH1 and MDH1 generally resulted in increased sensitivity to 3-BP also suggesting that preservation of the functional TCA cycle flux is important for preventing the 3-BP-induced toxicity. The Δkgd1 strain lacking the activity of mitochondrial alpha-ketoglutarate dehydrogenase is a respiratory deficient mutant and it does not utilize glycerol, however it has a functional respiratory chain and synthesis of other mitochondrial enzymes is not affected. In this mutant expression levels of aconitase, isocitrate dehydrogenase, succinate dehydrogenase and malate dehydrogenase as well as dihydrolipoyl dehydrogenase were not different from the wild-type [60]. It is possible that deletion of KGD1 as well as other genes encoding enzymes of the TCA cycle forward of the isocitrate dehydrogenase resulted in sensitivity to 3-BP due to activation of the glyoxylate cycle. This would be supported by the fact that deletion of the ICL1 gene, encoding isocitrate lyase (the crucial enzyme in the glyoxylate cycle), resulted in resistance to 3-BP.
Deletion of CIT3 gene, encoding a mitochondrial citrate synthase, has no effect on the citrate/methylcitrate synthase activity, as the other isoforms are active. However, Cit3p is essential for growth on propionate as a carbon and energy source. It was shown that Δcit3 exhibits unusual pyruvate metabolism with dramatic accumulation of acetate and isobutanol, which is probably caused by excessive mitochondrial propionyl-CoA, resulting in inhibition of the PDH E2 subunit [61]. The Δcit3 strain exhibited resistance to 3-BP which may be explained by the fact, that accumulation of acetate occurring in this strain may lead to the downregulation of pyruvate decarboxylation and increased which directs pyruvate rather to mitochondria or to the gluconeogenic pathway.
It was shown that deletion of MPC genes, encoding mitochondrial pyruvate carrier, results in impaired pyruvate metabolism, accumulation of upstream metabolites and depletion of TCA cycle intermediates. Δmpc mutants exhibited increased cytoplasmic pyruvate concentrations, depleted malate and acetyl-CoA, suggesting that they are unable to properly convert pyruvate to mitochondrial acetyl-CoA, which results in nonfunctional TCA cycle and impaired ATP production. Uptake assay on isolated mitochondria showed almost no uptake of 14C-pyruvate in the Δmpc1 strain [62]. The sensitivity to 3-BP of the Δmpc1 and Δlpd1, together with resistance of the Δpdc1, may suggest that increased activity of the PDH-bypass pathway possibly increases 3-BP toxicity.
Δpor1 and Δmir1 mutants, lacking mitochondrial porin and phosphate carrier (being the parts of the ATP-synthasome), show sensitivity to 3-BP, possibly due to partially disrupted respiration, as well as an imbalance of NAD/NADH, resulting in insufficient reducing buffer.
It can be concluded that when grown on medium with 3-BP, single mutants concerning the TCA cycle enzymes exhibit different phenotypes than rho0 strains, possibly due to the retrograde response activated in the latter. Generally, single deletions of genes encoding the TCA cycle enzymes and mitochondrial carriers resulted in increased sensitivity to 3-BP, whereas mutations in the glycolytic pathway resulted in increased resistance (Figures 8 and 9). On the other hand disruption of the pentose phosphate pathway resulted in increased sensitivity. It is probable that most of the effects of these mutations come down to the upregulation of gluconeogenesis and pentose phosphate pathway which is the main source of NADPH which provides the reducing potential for most of the antioxidant agents, such as glutathione, which has great influence on 3-BP susceptibility [26]. Moreover, also the TCA cycle replenishes the pool of NADPH through mitochondrial transhydrogenase, thus having an impact on cellular glutathione levels [63].

Figure 8: The influence of 3-BP on single yeast mutants having deleted genes encoding glycolytic and pentose phosphate pathway enzymes. Deletion of genes marked in: green resulted in increased resistance to 3-BP; red – increased sensitivity; blue – no changes comparing to wild-type.
Abbreviations: ADH1, alcohol dehydrogenase; ALD6, cytosolic aldehyde dehydrogenase; ENO1, enolase-1; ENO2, enolase-2; FBP1, fructose-1,6-bisphosphatase; GLK1, glucokinase; HXK1, hexokinase-1; HXK2, hexokinase-2; PCK1, phosphoenolpyruvate carboxykinase; PDC1, pyruvate decarboxylase-1; PFK1, phosphofructokinase alpha subunit; PFK2, phosphofructokinase beta subunit; PYC1, pyruvate carboxylase-1; PYC2, pyruvate carboxylase-2; PYK2, pyruvate kinase; TAL1, transaldolase; TDH1, 3-P-glyceraldehyde dehydrogenase-1; TDH2, 3-P-glyceraldehyde dehydrogenase-2; TDH3, 3-P-glyceraldehyde dehydrogenase-3; TKL1, transketolase; ZWF1, glucose-6-phosphate dehydrogenase.

Figure 9: The influence of 3-BP on single yeast mutants having deleted genes encoding TCA cycle and glyoxylate cycle enzymes, as well as mitochondrial carriers. Deletion of genes marked in: green resulted in increased resistance to 3-BP; red – increased sensitivity; blue – no changes comparing to wild-type.
Abbreviations: ACO1, aconitase; ACO2, aconitate hydratase; CIT1, citrate synthase; CIT3, citrate synthase; CYB2, L-lactate cytochrome-c oxidoreductase; DLD1, D-lactate dehydrogenase; ICL1, isocitrate lyase; IDH1, NAD-dependent isocitrate dehydrogenase; IDH2, NAD-dependent isocitrate dehydrogenase; KGD1, alpha-ketoglutarate dehydrogenase; KGD2, alpha-ketoglutarate dehydrogenase; LPD1, dihydrolipoamide dehydrogenase; MDH1, mitochondrial malate dehydrogenase; MDH2, cytoplasmic malate dehydrogenase; MIR1, mitochondrial phosphate carrier; MLS1, malate synthase; MPC, mitochondrial pyruvate carrier; OAC1, oxaloacetate transporter; PDX1, pyruvate dehydrogenase complex protein X; POR1, mitochondrial porin (voltage-dependent anion channel); PYC1, pyruvate carboxylase-1; PYC2, pyruvate carboxylase-2; SDH1, succinate dehydrogenase.
It cannot be also excluded that 3-bomopyruvate could be recognized as a mimicking substrate for one or more enzymes engaged in metabolism of pyruvate. It has been shown in vitro that lactate dehydrogenase (LDH) may use 3-BP as a substrate, however with over 100-fold lower affinity than pyruvate (unpublished data).
Yeast cells grown on medium with high concentration of glucose during the logarithmic phase produce energy mainly by fermentation of glucose, whereas respiration and stress response mechanisms are repressed (the Crabtree effect). When glucose is exhausted the diauxic shift occurs, resulting in changes in expression levels of many proteins as well as the upregulation of stress response pathways [42]. Cells switch to metabolism of unfermentable carbon sources, gluconeogenic, TCA cycle, and glyoxylate shunt genes are induced [64]. The expression of PCK1 (phosphoenolpyruvate carboxykinase), FBP1 (fructose-1,6-bisphosphatase), MDH2 (malate dehydrogenase), as well as ICL1 (isocitrate lyase) and MLS1 (malate synthase) are upregulated during glucose depletion [65]. In yeast the Ras-cAMP-PKA signaling pathway is essential for the diauxic shift, it also regulates mitochondrial function and ROS production. PKA (cAMP-dependent protein kinase) is inactive during unfermenting growth and is activated when glucose becomes abundant and lack of PKA results in defective glucose repression [66]. The Δtpk1 strain, lacking the subunit of PKA, shows increased sensitivity to 3-BP, which may be due to the defect in glucose repression mechanism. In yeast cells grown in the absence of glucose, on media with alternative sugars, such as sucrose, galactose, and maltose, Mig1p repressor activity is inhibited. In the presence of glucose Mig1p factor localizes to the nucleus repressing expression of target genes such as SUC2 encoding invertase [42]. Cat8p is one of the factors required for activation of gluconeogenesis during growth on unfermetable carbon sources, therefore Δcat8 cells are unable to grow on unfermentable carbon sources [69]. CAT8 transcription is inhibited by Mig1p and activated by the Hap2/3/4/5p complex. Δcat8 mutant, exhibited increased resistance to 3-BP, whereas Δmig1 strain, having defective glucose repression, showed increased sensitivity to 3-BP when grown on sucrose. Similarly, the Δyck1 strain, exhibiting faulty respiration repression by glucose [39, 40], showed increased sensitivity to 3-BP. These results confirm that glucose repression reduces sensitivity to 3-BP, which effect is clearly visible in wild-type strains grown on glucose.
PKA is also engaged in activation of metabolic flux through glycolysis. PKA activates phosphofructokinase-2 (PFK2) [67], and indirectly also pyruvate kinase (PYK2) through increased production of fructose-2,6 bisphosphate which is an allosteric activator of pyruvate kinase [68]. PKA also phosphorylates the key gluconeogenic enzyme fructose-1,6-bisphosphatase (FBP1) leading to its degradation [42]. Sensitivity of Δtpk1 cells to 3-BP may be connected to its interaction with phosphofructokinase-2 and pyruvate kinase. Lack of PKA activity causes decreased activity if these enzymes giving phenotypic effect similar to deletion of the corresponding genes. This however seems not to be the case, as both Δpfk2 and Δpyk2 strains exhibited increased resistance to 3-BP.
The most probable pathway of PKA influence on 3-BP susceptibility is connected with Whi2p phosphatase and the mechanism of mitophagy. Cells without functional Whi2p fail to enter the stationary phase. Whi2p was suggested to be engaged in the cell cycle control, as Δwhi2 cells fail to enter G1 and arrest randomly within the cell cycle in stationary phase [45]. These cells also fail to sense nutritional deprivation, leading to continuous proliferation. Sensitivity to 3-BP of the Δwhi2 which was visible even when grown on medium with glucose, may be due to faulty glucose-repression system in this mutant. Whi2p together with Psr1p and Psr2p mediate the general response to environmental stress through the Msn2p/Msn4p factors [43]. It can, however, be excluded that WHI2-related sensitivity to 3-BP is a consequence of disrupted general stress response pathway, as the Δmsn2/Δmsn4 and Δhog1 strains do not exhibit sensitivity to 3-BP. Deletion of PSR1 and PSR2 genes encoding Whi2p binding partners resulted in increased sensitivity suggesting, that Psr1p/Psr2p are required for the Wh2p-mediated response to 3-BP.
Moreover, it was shown that lack of Whi2p leads to actin aggregation, which is thought to induce apoptosis, probably occurring on the Ras-cAMP-PKA pathway [42]. Δwhi2 cells exhibit nuclear fragmentation and loss of mitochondrial DNA during diauxic shift. The Δwhi2 strain was shown to be sensitive to 2 mM H2O2, unlike the wild-type. Mitochondria in Δwhi2 cells were reported to have reduced membrane potential, exhibit fragmentation and production of high levels of ROS during the diauxic shift [42]. It has been recently explained to be a consequence of defective mitophagy on the Ras-cAMP-PKA pathway in Δwhi2 cells, resulting in reduced elimination of damaged mitochondria [45]. This seems to be the most probable reason for 3-BP-sensitivity of Δwhi2 and Δtpk1 (PKA) strains.
As the turnover of Jen1p was shown to be regulated through phosphorylation by the Yck1p kinase [69], it was possible that the phosphatase activity of Whi2p could influence the activity of Jen1p. This however is not the case, as the double Δjen1Δwhi2 mutant shows similar increase in resistance to 3-BP comparing to the single Δwhi2, as the Δjen1 mutant to wild-type.
Concluding, this study shows the multidirectional influence of 3-BP on metabolism in yeast. The lack of glucose-repression mechanism activity is crucial for 3-BP toxicity, which is mainly due to ATP depletion. Glucose present in the culturing medium, as well as genetic disruption of the glucose-repression system decreases toxic activity of 3-BP. Generally single deletions of genes encoding the TCA cycle enzymes and mitochondrial carriers cause sensitivity to 3-BP. Disruption of the pentose phosphate pathway results in increased sensitivity to 3-BP, probably due to the fact that PPP is a main source of NADPH which provides the reducing potential for most of the antioxidant agents, including glutathione. Most of the effects on 3-BP-sensitivity of the single disruptions in glycolytic and TCA pathways may probably be explained by down- or upregulation of the gluconeogenesis and pentose phosphate pathway and its influence on the reducing buffer of the cell. Presence of yeast Whi2p phosphatase is essential for resistance phenotype to 3-BP, probably because of its interaction with glucose-repression mechanism and the mitophagy of damaged mitochondria through the Ras-cAMP-PKA pathway. It is noteworthy that Whi2-mediated resistance to 3-BP does not occur through the HOG stress response pathway. Moreover, the effect of 3-BP resistance caused by disruption of the Jen1p transporter disruption is independent of the sensitivity effect caused by the deletion of WHI2 gene. The results obtained in this study may help elucidate the mechanisms of activity of 3-BP on glycolytic and TCA enzymes as well as its influence on yeast mitochondria and glucose repression system. However, further research is needed concerning the influence of faulty mitophagy on 3-BP toxicity. These findings may help to better understand the toxic activity of 3-BP and improve its effectiveness as an anticancer and antifungal drug.
MATERIALS AND METHODS
Yeast and bacterial strains used in this study
The yeast Saccharomyces cerevisiae haploid strains used in this study are listed in Table 4.
Table 2: Plasmids used in this study
Plasmid |
Description |
Reference |
|---|---|---|
pFL44L |
YE-type high copy number shuttle vector, URA3, AmpR |
Bonneaud et al. [72] |
pFA6a-kanMX6 |
Vector containing kanMX6 cassette for gene deletion, AmpR |
Wach et al. [77] |
pFA6a-TRP1 |
Vector containing TRP1 cassette for gene deletion, AmpR |
Longtine et al. [73] |
BPR1 |
pFL44L containing ~4000bp fragment of XV yeast chromosome containing the complete WHI2 gene and a fragment of CUE5 gene |
This study |
Table 3: Primers used in this study
Primer |
Sequence 5’ – 3’ |
|---|---|
WHI2F1 |
ATGGACGATATAATCACGCAAGTTTCTCCAGATAATGCAGCGGATCCCCGGGTTAATTAA |
WHI2R1 |
TCACTGCACCCCAATAACGCTCAACTCTAAAGTCCAAACTGAATTCGAGCTCGTTTAAAC |
WHI2PR |
GGCATAGTGATAGAGTGTGA |
WHI2INT1 |
TCCTGCTCATTGTTGCTCGA |
PSR1F1 |
ATGGGTTTCATATCGTCAATACTGTGCTGCTCTTCCGAGACGGATCCCCGGGTTAATTAA |
PSR1R1 |
TTATATTGTTACATCCAAAATTTTGCCCACATCCAGTGAGGAATTCGAGCTCGTTTAAAC |
PSR1PR |
AGGACGTATCACGTGACACAAAC |
PSR1INT1 |
GAAGTATCTTTCACAGCATC |
PSR2F1 |
ATGGGATTTATAGCAAATATACTGTGCTGTTCTTCAGATACGGATCCCCGGGTTAATTAA |
PSR2R1 |
CTATATCGTCACATCCAACACGCTCCCCACATCCAACACGGAATTCGAGCTCGTTTAAAC |
PSR2PR |
TATCTTTTTCGCAGCGCGTA |
PSR2INT1 |
AGACAAAAGGATCTCCGGTGT |
PKAN |
GATTGCCCGACATTATCGCGAG |
PTRP1 |
GTTGCAGTCTTTTGGAAATAC |
PTRP2 |
CTCCAAGCTGCCTTTGTGTG |
M13FWD |
GTAAAACGACGGCCAGT |
M13REV |
CAGGAAACAGCTATGAC |
Table 4: Yeast strains used in this study
Strain |
Genotype |
Reference |
|---|---|---|
W303-1A |
MAT a, ade2-1, leu2-112, his3-11,15, trp1-1, ura3-1 |
Rothstein & Thomas [70] |
W303-1A rho0 |
W303-1A, rho0 |
This study |
Δjen1 (BLC203) |
W303-1A, Δjen1::HIS3 |
Casal et al. [43] |
Δwhi2 |
W303-1A, Δwhi2::KanMX6 |
This study |
Δjen1Δwhi2 |
W303-1A, Δjen1::HIS3, Δwhi2::KanMX6 |
This study |
Δpsr1 |
W303-1A, Δpsr1::KanMX6 |
This study |
Δpsr2 |
W303-1A, Δpsr2::KanMX6 |
This study |
Δpsr1Δpsr2 |
W303-1A, Δpsr1::KanMX6, Δpsr2::TRP1 |
This study |
BY4741 |
MAT a, Δhis3; Δleu2; Δmet15; Δura3 |
Euroscarf |
Δwhi2 |
BY4741, Δwhi2 |
Euroscarf |
Δpsr1 |
BY4741, Δpsr1 |
Euroscarf |
Δmsn2 |
BY4741, Δmsn2 |
Euroscarf |
Δmsn4 |
BY4741, Δmsn4 |
Euroscarf |
Δhog1 |
BY4741, Δhog1 |
Euroscarf |
Δhxk1 |
BY4741, Δhxk1 |
Euroscarf |
Δhxk2 |
BY4741, Δhxk2 |
Euroscarf |
Δglk1 |
BY4741, Δglk1 |
Euroscarf |
Δpfk2 |
BY4741, Δpfk2 |
Euroscarf |
Δaco2 |
BY4741, Δaco2 |
Euroscarf |
Δtdh1 |
BY4741, Δtdh1 |
Euroscarf |
Δpyk2 |
BY4741, Δpyk2 |
Euroscarf |
Δkgd1 |
BY4741, Δkgd1 |
Euroscarf |
Δidh2 |
BY4741, Δidh2 |
Euroscarf |
Δcit3 |
BY4741, Δcit3 |
Euroscarf |
Δpyc2 |
BY4741, Δpyc2 |
Euroscarf |
Δkgd2 |
BY4741, Δkgd2 |
Euroscarf |
Δpyc1 |
BY4741, Δpyc1 |
Euroscarf |
Δtdh3 |
BY4741, Δtdh3 |
Euroscarf |
Δaco1 |
BY4741, Δaco1 |
Euroscarf |
Δidh1 |
BY4741, Δidh1 |
Euroscarf |
Δcit1 |
BY4741, Δcit1 |
Euroscarf |
Δlpd1 |
BY4741, Δlpd1 |
Euroscarf |
Δpfk1 |
BY4741, Δpfk1 |
Euroscarf |
Δtdh2 |
BY4741, Δtdh2 |
Euroscarf |
Δaco2 |
BY4741, Δaco2 |
Euroscarf |
Δeno1 |
BY4741, Δeno1 |
Euroscarf |
Δeno2 |
BY4741, Δeno2 |
Euroscarf |
Δdld1 |
BY4741, Δdld2 |
Euroscarf |
Δcyb2 |
BY4741, Δcyb2 |
Euroscarf |
Δpdc1 |
BY4741, Δpdc1 |
Euroscarf |
Δpdx1 |
BY4741, Δpdx1 |
Euroscarf |
Δadh1 |
BY4741, Δadh1 |
Euroscarf |
Δacs1 |
BY4741, Δacs1 |
Euroscarf |
Δald4 |
BY4741, Δald4 |
Euroscarf |
Δald6 |
BY4741, Δald6 |
Euroscarf |
Δmpc1 |
BY4741, Δmpc1 |
Euroscarf |
Δmpc2 |
BY4741, Δmpc2 |
Euroscarf |
Δmpc3 |
BY4741, Δmpc3 |
Euroscarf |
Δpor1 |
BY4741, Δpor1 |
Euroscarf |
Δmir1 |
BY4741, Δmir1 |
Euroscarf |
Δoac1 |
BY4741, Δoac1 |
Euroscarf |
Δicl1 |
BY4741, Δicl1 |
Euroscarf |
Δsdh1 |
BY4741, Δsdh1 |
Euroscarf |
Δzwf1 |
BY4741, Δzwf1 |
Euroscarf |
Δmls1 |
BY4741, Δmls1 |
Euroscarf |
Δmdh1 |
BY4741, Δmdh1 |
Euroscarf |
Δmdh2 |
BY4741, Δmdh2 |
Euroscarf |
Δtal1 |
BY4741, Δtal1 |
Euroscarf |
Δfbp1 |
BY4741, Δfbp1 |
Euroscarf |
Δtkl1 |
BY4741, Δtkl1 |
Euroscarf |
Δpck1 |
BY4741, Δpck1 |
Euroscarf |
Δtpk1 |
BY4741, Δtpk1 |
Euroscarf |
Δmig1 |
BY4741, Δmig1 |
Euroscarf |
Δcat8 |
BY4741, Δcat8 |
Euroscarf |
Δyck1 |
BY4741, Δyck1 |
Euroscarf |
The yeast deletion mutants used in this study were isogenic to one of the two parental strains, i.e., W303-1A [70] or BY4741. The wild type BY4741 strain and its deletion mutants were purchased from the EUROSCARF collection (www.uni-frankfurt.de/fb15/mikro/euroscarf).
Escherichia coli JM109 (endA1, recA1, gyrA96, thi, hsdR17(rk-, mk+)supE44, λ-, Δ(lac – proAB), [F’, traD36, proAB, lacIqZM15] strain (Promega) was used for multiplication of plasmids.
Media and growth conditions
Saccharomyces cerevisiae strains were cultured on YPD medium: 1% yeast extract (Becton, Dickinson & Company®), 2% peptone (Becton, Dickinson & Company®), 2% glucose (Chempur®), YP10 medium: 1% yeast extract (Becton, Dickinson & Company®), 2% peptone (Becton, Dickinson & Company®), 10% glucose (Chempur®) and N3 medium 1% yeast extract (Becton, Dickinson & Company®), 2% peptone (Becton, Dickinson & Company®), 2% glycerol (Chempur®). The spot-tests were performed using minimal synthetic (SD) medium with sucrose: 0.67% Yeast Nitrogen Base (Becton, Dickinson & Company®), 2% sucrose (Chempur®). The media were supplemented with uracil, adenine, histidine, leucine, tryptophane (Sigma®) at the concentration 10 μg/ml, when needed. Complete YPD medium with 200 μg/ml of geneticin (G418, Sigma-Aldrich) was used for selection of geneticin-resistant strains. To solidify the media 2% agar-agar was used (Becton, Dickinson & Company®). Yeast strains were grown at 28°C for 72, 96 and 120 hours, unless stated differently. Liquid cultures were grown overnight at 28°C and 160 rev./min [71].
Escherichia coli strain were cultured on LB medium: 1% bactotrypton (Becton, Dickinson & Company®), 1% yeast extract (Becton, Dickinson & Company®), 0,5% NaCl (Chempur®). When needed the medium was supplemented with ampicillin (Sigma-Aldrich) to the concentration of 100 μg/ml. To solidify the media 2% agar-agar was used (Becton, Dickinson & Company®). All bacterial strains were cultured at 37°C and 200 rev./min.
Other chemicals and reagents
3-bromopyruvic acid, PEG and lithium acetate were purchased from Sigma-Aldrich (USA).
Plasmids and primers
Plasmids and primers used in this study are presented in Tables 2 and 3 [72, 73]. Synthesis of primers was performed by Genomed (Warsaw, Poland).
Yeast genomic DNA library in the pFL44L plasmid was used (Lacroute, Gif-sur-Yvette).
Plasmid preparation, E. coli transformation and agarose gel electrophoresis were carried out as described in Sambrook and Russel [74].
Isolation of plasmid DNA was performed using standard alkaline lysis method or with Plasmid Mini Kit (A&A Biotechnology), according to the product manual.
Spot-test method
To determine the MIC values (minimal inhibitory concentrations) of a tested compound toward the selected yeast strain and to compare the relative susceptibility of several strains, the cells were grown to mid-log phase, diluted to OD600≈0.25 and spotted (3 μl) in 10-fold serial dilutions (100, 10-1, 10-2) onto the agar plates containing various concentrations of a tested compound. Plates were incubated at 28°C and photographed after 72 h, 96 h or 120 h, depending when the phenotypic effect was most visible. The sensitivity assays were repeated a minimum of three times. Differences in growth show variability of the tested strain in their susceptibility to the tested inhibitor [34]. Spot tests were performed on minimal (YNB) medium with sucrose as a carbon source, unless stated differently.
Determination of intracellular ATP levels in yeast cells
ATP level were determined for cells cultivated in liquid SD medium with sucrose at 28°C. The 24h cultures were diluted to optical density OD600 = 0.25 with fresh SD medium. The cultures were then incubated in medium with 1.8 mM and 3 mM 3-BP and as a control in medium without 3-BP. At the start-point and after 1, 2, 3, 5 hours of incubation, 50 μl of cell culture were lysed and the ATP level was determined using the ATPlite™ Luminescence Assay System (PerkinElmer) and PerkinElmer EnSpire® Multimode Plate Reader. ATP levels at each time-point were calculated as a percentage of the positive control (without 3-BP) and were recalculated per living cells. Viability of the cells at each time-point was determined by plating a 100 μl sample of culture (using appropriate culture dilutions if necessary) on YPD medium. Colonies were counted after 72h of incubation at 28°C. The experiment was repeated a minimum of three times.
Rho0 generation
To obtain the rho0 respiratory deficient mutant the parental strain was incubated in liquid YP10 medium with ethidium bromide (30 ug/ml) for 24 hours at 28°C. After incubation cells were plated on the YPD medium. The mutants were identified by colony size and confirmed by the lack of growth on medium with glycerol (N3) [75].
High efficiency yeast transformation
Yeast high efficiency and one-step transformation were performed by the lithium acetate procedure [76].
Yeast colony PCR
A yeast colony taken from an agar plate was suspended in 0.02 M NaOH solution. The sample was then boiled for 5 minutes and cooled on ice. After short centrifugation the supernatant was used for the PCR amplification. PCR were performed using Taq DNA Polymerase (Thermo Scientific).
Construction of yeast deletion-mutants
Deletion mutants in the W303-1A background were constructed using the method based on homologous integration of disruption cassettes described by Wach et al. [77]. The cassettes (KanMX6 and TRP1) were amplified by PCR with gene-specific primers using the following PCR program: 1:00 initial denaturation at 95°C, 30 cycles of 0:30 95°C, 0:30 65°C, 1:00 72°C and final extension of 5:00 at 72°C. The PCR product was then used for high-efficiency transformation of a specific yeast strain. Positive transformants were isolated using selective media: SD-trp for TRP1 cassette and YPD+G418 for KanMX6 cassette. To confirm successful deletion of chosen genes, total DNA was isolated from the transformed strain and control PCR reactions were performed with gene- and cassette-specific primers using the following PCR program: 1:00 initial denaturation at 95°C, 30 cycles of 0:30 95°C, 0:30 55°C, 1:00 72°C and final extension of 5:00 at 72°C. PCR were performed using Taq DNA Polymerase (Thermo Scientific).
Search for multicopy suppressors of the resistant phenotype using yeast genomic DNA library
FY1679-28C was transformed with genomic DNA library (multicopy pFL44L plasmid) using high efficiency transformation, plated on SD medium without uracil (100 plates) and incubated for 48 hours. Grown transformants (200-300 colonies per plate) were then replicated on plates with SD medium containing 3 mM 3-BP and incubated for 120 hours. Total DNA was isolated from resistant transformants and used for transformation of E.coli JM109 to select and isolate plasmid DNA from total DNA. Isolated plasmids were sequenced using M13FWD and M13REV primers (Genomed, Warsaw, Poland) and used for retransformation of yeast, to confirm the resistant phenotype.
Statistical analysis
The results represent the mean ± SD from at least three independent experiments. Statistical significance was assessed by 1-way ANOVA using GraphPad Prism5, and with Tukey’s multiple comparison test.
ACKNOWLEDGMENTS
The authors are indebted to Dr Lucyna Chmielewska for technical help with the strains purchased from the Euroscarf collection. We are also grateful to Magdalena Lisowska–Rosol /Key Account Manager Life Sciences & Technology from PerkinElmer Poland/ for providing the ATPlite™ Luminescence Assay System (PerkinElmer) and PerkinElmer EnSpire® Multimode Plate Reader.
CONFLICTS OF INTEREST
The authors declare no conflicts of interest.
FUNDING
This work was supported by the Ministry of Science and Higher Education (Poland) within of “Statutory Research 1016/S/IGM”.
REFERENCES
1. Khurana V, Lindquist S. Modelling neurodegeneration in Saccharomyces cerevisiae: why cook with baker's yeast? Nat Rev Neurosci. 2010; 11:436-49.
2. Tosato V, Grüning NM, Breitenbach M, Arnak R, Ralser M, Bruschi CV. Warburg effect and translocation-induced genomic instability: two yeast models for cancer cells. Front Oncol. 2012; 2:212.
3. Goffeau A, Barrell BG, Bussey H, Davis RW, Dujon B, Feldmann H, Galibert F, Hoheisel JD, Jacq C, Johnston M, Louis EJ, Mewes HW, Murakami Y, Philippsen P, Tettelin H, Oliver SG. Life with 6000 genes. Science. 1996; 274:546, 563-7.
4. Jones GM, Stalker J, Humphray S, West A, Cox T, Rogers J, Dunham I, Prelich G. A systematic library for comprehensive overexpression screens in Saccharomyces cerevisiae. Nat Methods. 2008; 5:239-41.
5. Hartwell LH. Nobel Lecture. Yeast and cancer. Biosci Rep. 2002; 22:373-94.
6. Carmona-Gutierrez D, Ruckenstuhl C, Bauer MA, Eisenberg T, Büttner S, Madeo F. Cell death in yeast: growing applications of a dying buddy. Cell Death Differ. 2010; 17:733-4.
7. Pereira C, Coutinho I, Soares J, Bessa C, Leão M, Saraiva L. New insights into cancer-related proteins provided by the yeast model. FEBS J. 2012; 279:697-712.
8. Hartwell LH. Yeast and cancer. Biosci Rep. 2004; 24:523-44.
9. Matuo R, Sousa FG, Soares DG, Bonatto D, Saffi J, Escargueil AE, Larsen AK, Henriques JA. Saccharomyces cerevisiae as a model system to study the response to anticancer agents. Cancer Chemother Pharmacol. 2012; 70:491-502.
10. Entian KD, Fröhlich KU, Mecke D. Regulation of enzymes and isoenzymes of carbohydrate metabolism in the yeast Saccharomyces cerevisiae. Biochim Biophys Acta. 1984; 799:181-6.
11. Boles E, Schulte F, Miosga T, Freidel K, Schlüter E, Zimmermann FK, Hollenberg CP, Heinisch JJ. Characterization of a glucose-repressed pyruvate kinase (Pyk2p) in Saccharomyces cerevisiae that is catalytically insensitive to fructose-1,6-bisphosphate. J Bacteriol. 1997; 179:2987-93.
12. Diaz-Ruiz R, Uribe-Carvajal S, Devin A, Rigoulet M. Tumor cell energy metabolism and its common features with yeast metabolism. Biochim Biophys Acta. 2009;1796:252-65.
13. Gey U, Czupalla C, Hoflack B, Rödel G, Krause-Buchholz U. Yeast pyruvate dehydrogenase complex is regulated by a concerted activity of two kinases and two phosphatases. J Biol Chem. 2008; 283:9759-67.
14. Krause-Buchholz U, Gey U, Wünschmann J, Becker S, Rödel G. YIL042c and OR090c encode the kinase and phosphatase of the Saccharomyces cerevisiae pyruvate dehydrogenase complex. FEBS Lett. 2006; 580:2553-60.
15. Roy DJ, Dawes IW. Cloning and characterization of the gene encoding lipoamide dehydrogenase in Saccharomyces cerevisiae. J Gen Microbiol. 1987; 133:925-33.
16. Pallotta ML, Valenti D, Iacovino M, Passarella S. Two separate pathways for d-lactate oxidation by Saccharomyces cerevisiae mitochondria which differ in energy production and carrier involvement. Biochim Biophys Acta. 2004; 1608:104-13.
17. Hohmann S, Cederberg H. Autoregulation may control the expression of yeast pyruvate decarboxylase structural genes PDC1 and PDC5. Eur J Biochem. 1990; 188:615-21.
18. Boubekeur S, Bunoust O, Camougrand N, Castroviejo M, Rigoulet M, Guérin B. A mitochondrial pyruvate dehydrogenase bypass in the yeast Saccharomyces cerevisiae. J Biol Chem. 1999; 274:21044-8.
19. Van Urk H, Voll WS, Scheffers WA, Van Dijken JP. Transient-state analysis of metabolic fluxes in crabtree-positive and crabtree-negative yeasts. Appl Environ Microbiol. 1990; 56:281-7.
20. Pedersen PL, Mathupala S, Rempel A, Geschwind JF, Ko YH. Mitochondrial bound type II hexokinase: a key player in the growth and survival of many cancers and an ideal prospect for therapeutic intervention. Biochim Biophys Acta. 2002; 1555:14-20.
21. Geschwind JF, Georgiades CS, Ko YH, Pedersen PL. Recently elucidated energy catabolism pathways provide opportunities for novel treatments in hepatocellular carcinoma. Expert Rev Anticancer Ther. 2004; 4:449-57.
22. Ko YH, Smith BL, Wang Y, Pomper MG, Rini DA, Torbenson MS, Hullihen J, Pedersen PL. Advanced cancers: eradication in all cases using 3-bromopyruvate therapy to deplete ATP. Biochem Biophys Res Commun. 2004; 324:269-75.
23. Mathupala SP, Ko YH, Pedersen PL. Hexokinase-2 bound to mitochondria: cancer’s stygian link to the “Warburg Effect” and a pivotal target for effective therapy. Semin Cancer Biol. 2009; 19:17-24.
24. Ganapathy-Kanniappan S, Kunjithapatham R, Geschwind JF. Anticancer efficacy of the metabolic blocker 3-bromopyruvate: specific molecular targeting. Anticancer Res. 2013;33:13-20.
25. Ihrlund LS, Hernlund E, Khan O, Shoshan MC. 3-Bromopyruvate as inhibitor of tumour cell energy metabolism and chemopotentiator of platinum drugs. Mol Oncol. 2008; 2:94-101.
26. Lis P, Zarzycki M, Ko YH, Casal M, Pedersen PL, Goffeau A, Ułaszewski S. Transport and cytotoxicity of the anticancer drug 3-bromopyruvate in the yeast Saccharomyces cerevisiae. J Bioenerg Biomembr. 2012; 44:155-61.
27. Sadowska-Bartosz I, Bartosz G. The effect of 3-bromopyruvic acid on human erythrocyte antioxidant defense system. Cell Biol Int. 2013; 37:1285-90.
28. Queirós O, Preto A, Pacheco A, Pinheiro C, Azevedo-Silva J, Moreira R, Pedro M, Ko YH, Pedersen PL, Baltazar F, Casal M. Butyrate activates the monocarboxylate transporter MCT4 expression in breast cancer cells and enhances the antitumor activity of 3-bromopyruvate. J Bioenerg Biomembr. 2012; 44:141-53.
29. Birsoy K, Wang T, Possemato R, Yilmaz OH, Koch CE, Chen WW, Hutchins AW, Gultekin Y, Peterson TR, Carette JE, Brummelkamp TR, Clish CB, Sabatini DM. MCT1-mediated transport of a toxic molecule is an effective strategy for targeting glycolytic tumors. Nat Genet. 2013; 45:104-8.
30. Majkowska-Skrobek G, Augustyniak D, Lis P, Bartkowiak A, Gonchar M, Ko YH, Pedersen PL, Goffeau A, Ułaszewski S. Killing multiple myeloma cells with the small molecule 3-bromopyruvate: implications for therapy. Anticancer Drugs. 2014; 25:673-82.
31. Sadowska-Bartosz I, Soszyński M, Ułaszewski S, Ko Y, Bartosz G. Transport of 3-bromopyruvate across the human erythrocyte membrane. Cell Mol Biol Lett. 2014; 19:201 – 214.
32. Dyląg M, Lis P, Niedźwiecka K, Ko YH, Pedersen PL, Goffeau A, Ułaszewski S. 3-Bromopyruvate: a novel antifungal agent against the human pathogen Cryptococcus neoformans. Biochem Biophys Res Commun. 2013; 434:322-7.
33. Reddi AR, Culotta VC. SOD1 integrates signals from oxygen and glucose to repress respiration. Cell. 2013; 152:224-35.
34. Pasula S, Chakraborty S, Choi JH, Kim JH. Role of casein kinase 1 in the glucose sensor-mediated signaling pathway in yeast. BMC Cell Biol. 2010; 7;11:17.
35. Radcliffe PA, Binley KM, Trevethick J, Hall M, Sudbery PE. Filamentous growth of the budding yeast Saccharomyces cerevisiae induced by overexpression of the WHI2 gene. Microbiology. 1997; 143:1867-76.
36. Leadsham JE, Miller K, Ayscough KR, Colombo S, Martegani E, Sudbery P, Gourlay CW. Whi2p links nutritional sensing to actin-dependent Ras-cAMP-PKA regulation and apoptosis in yeast. J Cell Sci. 2009; 122:706-15.
37. Kaida D, Yashiroda H, Toh-e A, Kikuchi Y. Yeast Whi2 and Psr1-phosphatase form a complex and regulate STRE-mediated gene expression. Genes Cells. 2002; 7:543-52.
38. Radcliffe PA, Trevethick J, Tyers M, Sudbery P. Deregulation of CLN1 and CLN2 in the Saccharomyces cerevisiae whi2 mutant. Yeast. 1997; 13:707-15.
39. Mendl N, Occhipinti A, Müller M, Wild P, Dikic I, Reichert AS. Mitophagy in yeast is independent of mitochondrial fission and requires the stress response gene WHI2. J Cell Sci. 2011; 124:1339-50.
40. Siniossoglou S, Hurt EC, Pelham HR. Psr1p/Psr2p, two plasma membrane phosphatases with an essential DXDX(T/V) motif required for sodium stress response in yeast. J Biol Chem. 2000; 275:19352-60.
41. Sadeh A, Movshovich N, Volokh M, Gheber L, Aharoni A. Fine-tuning of the Msn2/4-mediated yeast stress responses as revealed by systematic deletion of Msn2/4 partners. Mol Biol Cell. 2011; 22:3127-38.
42. Martínez-Pastor MT, Marchler G, Schüller C, Marchler-Bauer A, Ruis H, Estruch F. The Saccharomyces cerevisiae zinc finger proteins Msn2p and Msn4p are required for transcriptional induction through the stress response element (STRE). EMBO J. 1996; 15:2227-35.
43. Casal M, Paiva S, Andrade RP, Gancedo C, Leão C. The lactate-proton symport of Saccharomyces cerevisiae is encoded by JEN1. J Bacteriol. 1999; 181:2620-3.
44. Pedersen PL. 3-Bromopyruvate (3BP) a fast acting, promising, powerful, specific, and effective “small molecule” anti-cancer agent taken from labside to bedside: introduction to a special issue. J Bioenerg Biomembr. 2012; 44:1-6.
45. Guaragnella N, Zdralević M, Lattanzio P, Marzulli D, Pracheil T, Liu Z, Passarella S, Marra E, Giannattasio S. Yeast growth in raffinose results in resistance to acetic-acid induced programmed cell death mostly due to the activation of the mitochondrial retrograde pathway. Biochim Biophys Acta. 2013; 1833:2765-2774.
46. Moye-Rowley WS. Retrograde regulation of multidrug resistance in Saccharomyces cerevisiae. Gene. 2005; 354:15-21.
47. Panwar SL, Moye-Rowley WS. Long chain base tolerance in Saccharomyces cerevisiae is induced by retrograde signals from the mitochondria. J Biol Chem. 2006; 281:6376-84.
48. Del Giudice L, Massardo DR, Pontieri P, Wolf K. Interaction between yeast mitochondrial and nuclear genomes: null alleles of RTG genes affect resistance to the alkaloid lycorine in rho0 petites of Saccharomyces cerevisiae. Gene. 2005; 354:9-14.
49. Epstein CB, Waddle JA, Hale W 4th, Davé V, Thornton J, Macatee TL, Garner HR, Butow RA. Genome-wide responses to mitochondrial dysfunction. Mol Biol Cell. 2001; 12:297-308.
50. Jitrapakdee S, Adina-Zada A, Besant PG, Surinya KH, Cleland WW, Wallace JC, Attwood PV. Differential regulation of the yeast isozymes of pyruvate carboxylase and the locus of action of acetyl CoA. Int J Biochem Cell Biol. 2007; 39:1211-23.
51. Rodríguez A, De La Cera T, Herrero P, Moreno F. The hexokinase 2 protein regulates the expression of the GLK1, HXK1 and HXK2 genes of Saccharomyces cerevisiae. Biochem J. 2001; 355:625-31.
52. Matsushika A, Goshima T, Fujii T, Inoue H, Sawayama S, Yano S. Characterization of non-oxidative transaldolase and transketolase enzymes in the pentose phosphate pathway with regard to xylose utilization by recombinant Saccharomyces cerevisiae. Enzyme Microb Technol. 2012; 51:16-25.
53. Grant CM. Metabolic reconfiguration is a regulated response to oxidative stress. J Biol. 2008; 7:1.
54. Slekar KH, Kosman DJ, Culotta VC. The yeast copper/zinc superoxide dismutase and the pentose phosphate pathway play overlapping roles in oxidative stress protection. J Biol Chem. 1996; 271:28831-6.
55. Gorsich SW, Dien BS, Nichols NN, Slininger PJ, Liu ZL, Skory CD. Tolerance to furfural-induced stress is associated with pentose phosphate pathway genes ZWF1, GND1, RPE1, and TKL1 in Saccharomyces cerevisiae. Appl Microbiol Biotechnol. 2006; 71:339-49.
56. Mollapour M, Fong D, Balakrishnan K, Harris N, Thompson S, Schüller C, Kuchler K, Piper PW. Screening the yeast deletant mutant collection for hypersensitivity and hyper-resistance to sorbate, a weak organic acid food preservative. Yeast. 2004; 21:927-46.
57. Lloyd D, James CJ, Maitra PK. Mutations in phosphofructokinases alter the control characteristics of glycolysis in vivo in Saccharomyces cerevisiae. Yeast. 1992; 8:291-301.
58. Kitanovic A, Wölfl S. Fructose-1,6-bisphosphatase mediates cellular responses to DNA damage and aging in Saccharomyces cerevisiae. Mutat Res. 2006; 594:135-47.
59. Palmieri L, Vozza A, Agrimi G, De Marco V, Runswick MJ, Palmieri F, Walker JE. Identification of the yeast mitochondrial transporter for oxaloacetate and sulfate. J Biol Chem. 1999; 274:22184-90.
60. Repetto B, Tzagoloff A. Structure and regulation of KGD1, the structural gene for yeast alpha-ketoglutarate dehydrogenase. Mol Cell Biol. 1989; 9:2695-705.
61. Graybill ER, Rouhier MF, Kirby CE, Hawes JW. Functional comparison of citrate synthase isoforms from S. cerevisiae. Arch Biochem Biophys. 2007; 465:26-37.
62. Bricker DK, Taylor EB, Schell JC, Orsak T, Boutron A, Chen YC, Cox JE, Cardon CM, Van Vranken JG, Dephoure N, Redin C, Boudina S, Gygi SP, Brivet M, Thummel CS, Rutter J. A mitochondrial pyruvate carrier required for pyruvate uptake in yeast, Drosophila, and humans. Science. 2012; 337:96-100.
63. El Sayed SM, Mahmoud AA, El Sawy SA, Abdelaal EA, Fouad AM, Yousif RS, Hashim MS, Hemdan SB, Kadry ZM, Abdelmoaty MA, Gabr AG, Omran FM, Nabo MM, Ahmed NS. Warburg effect increases steady-state ROS condition in cancer cells through decreasing their antioxidant capacities (Anticancer effects of 3-bromopyruvate through antagonizing Warburg effect). Med Hypotheses. 2013; doi:pii:S0306-9877(13)00423-4. 10.1016/j.mehy.2013.08.024. [Epub ahead of print].
64. Broach JR. Nutritional control of growth and development in yeast. Genetics. 2012; 192:73-105.
65. Turcotte B, Liang XB, Robert F, Soontorngun N. Transcriptional regulation of nonfermentable carbon utilization in budding yeast. FEMS Yeast Res. 2010; 10:2-13.
66. Kim JH, Roy A, Jouandot D 2nd, Cho KH. The glucose signaling network in yeast. Biochim Biophys Acta. 2013; 1830:5204-10.
67. Dihazi H, Kessler R, Eschrich K. Glucose-induced stimulation of the Ras-cAMP pathway in yeast leads to multiple phosphorylations and activation of 6-phosphofructo-2-kinase. Biochemistry. 2003; 42:6275-82.
68. Portela P, Moreno S, Rossi S. Characterization of yeast pyruvate kinase 1 as a protein kinase A substrate, and specificity of the phosphorylation site sequence in the whole protein. Biochem J. 2006; 396:117-26.
69. Paiva S, Vieira N, Nondier I, Haguenauer-Tsapis R, Casal M, Urban-Grimal D. Glucose-induced ubiquitylation and endocytosis of the yeast Jen1 transporter: role of lysine 63-linked ubiquitin chains. J Biol Chem. 2009; 284:19228-36.
70. Thomas BJ, Rothstein R. Elevated recombination rates in transcriptionally active DNA. Cell. 1989; 56, 619-630.
71. Kaiser C, Michaeli S, Mitchel A. Methods in yeast genetics. A Cold Spring Harbor Laboratory Course Manual. 1994. Cold Spring Harbor Laboratory Press. Cold Spring Harbor, N.Y.
72. Bonneaud N, Ozier-Kalogeropoulos O, Li GY, Labouesse M, Minvielle-Sebastia L, Lacroute F. A family of low and high copy replicative, integrative and single-stranded S. cerevisiae/E. coli shuttle vectors. Yeast. 1991; 7:609-15.
73. Longtine MS, McKenzie A 3rd, Demarini DJ, Shah NG, Wach A, Brachat A, Philippsen P, Pringle JR. Additional modules for versatile and economical PCR-based gene deletion and modification in Saccharomyces cerevisiae. Yeast. 1998; 14:953-61.
74. Sambrook J, Russel D.W. Molecular cloning: a laboratory manual. 3rd ed. 2001. Cold Spring Harbor Laboratory Press, Cold Spring Harbor, N.Y.
75. Słonimski P.P., Perodin G., Groft J.H. Biochem. Biophys. Res. Comm. 330, 232, 1968.
76. Gietz RD, Schiestl RH. High-efficiency yeast transformation using the LiAc/SS carrier DNA/PEG method. Nat Protoc. 2007; 2:31-4.
77. Wach A, Brachat A, Pöhlmann R, Philippsen P. New heterologous modules for classical or PCR-based gene disruptions in Saccharomyces cerevisiae. Yeast. 1994; 10:1793-808.

